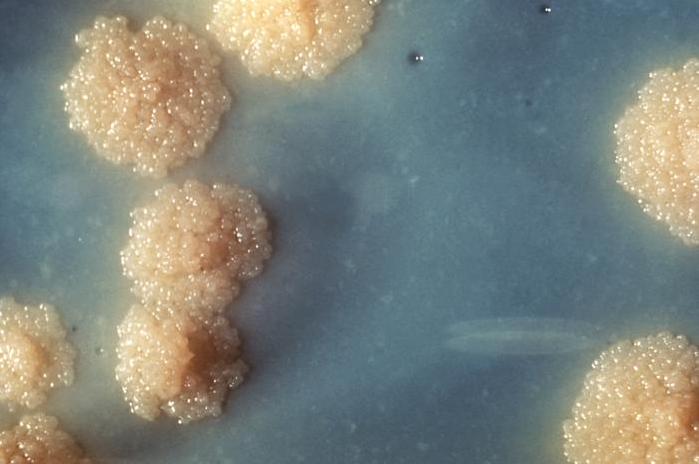

Cómo tratar la tuberculosis pulmonar


La tuberculosis pulmonar es una infección bacteriana contagiosa que afecta a los pulmones, pero puede propagarse a otros órganos. La falta de higiene y una alimentación poco saludable y desordenada suele ser la causa básica de esta afección pulmonar, aunque también se transmite con facilidad entre personas de forma directa.
Al principio la enfermedad puede presentarse como una simple dolencia respiratoria y, debido a ello, a la larga podría confundirse con la bronquitis crónica. Pero a medida que avanza la infección encontramos la presencia de tos seca, dificultad respiratoria, fiebre, sudores nocturnos, entre otros síntomas. Así, en unCOMO te contamos cómo tratar la tuberculosis pulmonar, principalmente con antibióticos, además de más información relevante sobre esta enfermedad.
Qué es la tuberculosis pulmonar y cómo se contagia
¿Qué es y qué causa la tuberculosis? Puede que estas sean las primeras dudas que nos vienen a la mente cuando oímos hablar de esta afección. Como hemos comentado ya, es una infección contagiosa causada por la bacteria Mycobacterium tuberculosis y es muy resistente. Ataca principalmente a los pulmones y otras partes del sistema respiratorio, pero si avanza porque no se trata puede terminar afectando a más órganos.
La tuberculosis se contagia fácilmente y, por ejemplo, se puede adquirir por la inhalación de partículas de saliva y mucosidad provenientes de la tos o del estornudo de una persona infectada. Aunque también podemos contagiarnos por el contacto con alimentos u objetos infectados, sobre todo en lugares con zonas insalubres o si tenemos una muy mala alimentación.
Hay algunas personas que presentan un mayor riesgo de padecer tuberculosis: los ancianos, los bebés y quienes tienen sistemas inmunitarios débiles.

Síntomas de la tuberculosis pulmonar
Es muy posible que durante la fase primaria de la enfermedad no haya síntomas, pero pasado este periodo aparecen diversos síntomas de la tuberculosis, como estos:
- Tos intensa y que dura 3 semanas o más
- Esputos con sangre o hamoptísicos
- Fatiga y debilidad
- Dolor en el pecho
- Pérdida de apetito
- Escalofríos
- Fiebre
- Sudores nocturnos
- Pérdida de peso
Pero la tuberculosis pulmonar también puede presentarse sin ninguna señal específica. En este caso, aunque aparentemente el paciente presenta una buena salud, escupe sangre.

Tratamiento para la tuberculosis pulmonar
Como la tuberculosis pulmonar está causada por una bacteria, el tratamiento estándar son los antibióticos o antibacterianos, además el médico suele recetar una combinación, siendo los más usados isoniacida y rifampicina. El médico puede ir realizando distintas pruebas a lo largo del tratamiento para ajustar mejor el que sea más efectivo en cada paciente. El tratamiento antibiótico suele durar mínimo 6 meses, aunque se sienten grandes mejorías a las pocas semanas. Además, se suele recomendar una dieta sana y equilibrada al paciente, la cual el médico ajusta a cada uno teniendo en cuenta más factores de la salud.
Durante las tres primeras semanas es necesario el aislamiento, aunque sea en casa, hasta que el tratamiento logra hacer suficiente efecto. Será necesaria la hospitalización y un tratamiento más específico en los casos graves de tuberculosis, sobre todo si ya afecta a otros órganos aparte de los pulmones.
El pronóstico de la tuberculosis si se descubre en sus fases más primarias y se trata adecuadamente es favorable, además se suele notar mejoría importante pasadas tres semanas del tratamiento. En cambio, si no se trata a tiempo o correctamente puede provocar daños permanentes en los pulmones, pudiendo ser de distinta gravedad, y llegar a extenderse la bacteria a otros órganos, lo que supone un gran riesgo para la salud y la vida.
Cuando el paciente ha completado el tratamiento, se suele realizar una prueba llamada espirometría para, de este modo, comprobar el estado de los pulmones y ver si se han recuperado por completo o han quedado dañados. Si el paciente recupera la función de los pulmones por completo o en su mayor parte, puede hacer vida totalmente normal. Además, el riesgo de volver a contagiarse no tiene nada que ver con haberla padecido, por lo que será el mismo para todo el mundo.
Cómo tratar la tuberculosis pulmonar naturalmente
Los mejores remedios naturales para la tuberculosis pulmonar son los que tienen potentes propiedades antibióticas o antibacterianas. Así, como complemento del tratamiento médico, conviene incluir en la alimentación, ya sea ingeridos en la comida o en infusiones, los siguientes alimentos y plantas:
- Ajo
- Cebolla
- Jengibre
- Romero
- Tomillo
- Propóleo
- Equinácea
- Espárragos
En este otro artículo de unCOMO te desvelamos más detalles sobre Cuáles son los antibióticos naturales.

Cómo prevenir la tuberculosis pulmonar
La tuberculosis se puede prevenir tomando las medidas necesarias para ello, tanto por parte del ya enfermo como por parte de quienes están sanos. Es necesario que al diagnosticarse la enfermedad y empezar el tratamiento, el paciente quede aislado durante 3 semanas, a modo de cuarentena, como hemos comentado antes, pero también pensando en evitar el contagio de la enfermedad y no solo en que el enfermo no se contagie de otros patógenos.
El enfermo de tuberculosis también tiene que usar una mascarilla y el contacto físico con otras personas debe ser limitado, con el mismo fin: tanto evitar la transmisión de esta bacteria como que el paciente contraiga otras infecciones. Quienes están sanos y deben relacionarse con el afectado para atenderle, tienen que protegerse bien, con ropa especial y mascarillas, y usar productos desinfectantes.
También son importantes los rayos del sol, por lo que conviene ventilar la habitación abriendo las ventanas pero manteniendo las puertas cerradas. El sol ayuda a reducir la bacteria en el ambiente.
Pasado este tiempo de aislamiento, se puede hacer una vida más normal, no es necesario usar mascarilla pero sí evitar aglomeraciones de gente, donde los contagios son más fáciles, además de seguir manteniendo una muy buena higiene y alimentación.
Este artículo es meramente informativo, en unCOMO no tenemos facultad para recetar ningún tratamiento médico ni realizar ningún tipo de diagnóstico. Te invitamos a acudir a un médico en el caso de presentar cualquier tipo de condición o malestar.
Si deseas leer más artículos parecidos a Cómo tratar la tuberculosis pulmonar, te recomendamos que entres en nuestra categoría de Enfermedades y efectos secundarios.